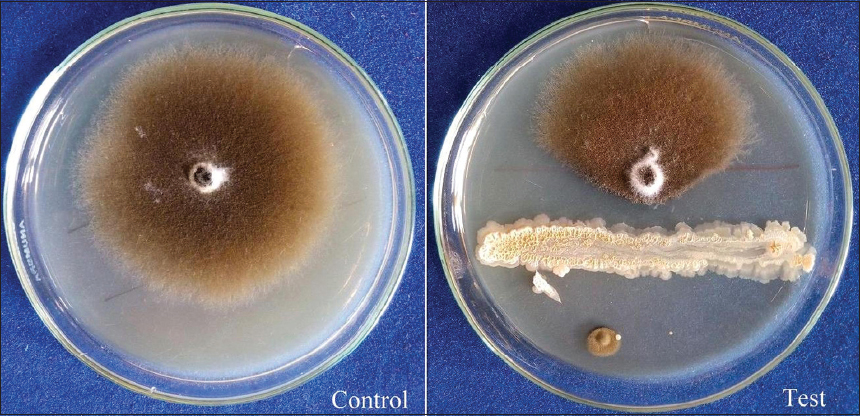

1. INTRODUCTION
Economically cotton is most crucial cash crop cultivated in all of the cotton growing areas of India and different countries of the world. Alternaria leaf spot disease is worldwide in distribution and mentioned [1] a major constraint in cotton production. The blended activity of Alternaria macrospora and Alternaria alternate results in the development of Alternaria leaf spot disease of cotton [2]. The transgenic and non-transgenic cotton hybrid varieties are equally susceptible to foliar diseases such as bacterial blight, Alternaria leaf spot, and gray mildew. Now a days in India, majority of the farmers cultivate Bt cotton instead of non-Bt cotton. This has created tremendous competitiveness in hybrid seed production as the production area for hybrid cotton has remained stagnant. In India, Alternaria leaf spot disease of cotton is common and reported variable percent disease incidence from South zones (10–35%), North zone (7.33–31.83%), and Central zone (9.66–31.30%). However, some environmental factors such as abiotic and biotic factors interfere the original productivity of crop. Among the biotic factors, several fungal phytopathogens are responsible to cause different types of foliar diseases and serve as major constrains in crop production. The yield loss up to 33.07% was recorded due to Alternaria leaf spot of cotton [3]. Conventionally, the farmers use agrochemicals to protect the crop and increase the crop yield. The tremendous use of agrochemicals leads to develop pest resistance, kills beneficial microflora of soil as well as pollution of soil.
Considering the alarming situation of Alternaria leaf spot disease, to avoid yield losses and hazardous effect of agrochemicals, the plant pathologist diverted their research to find out the naturally occurring rhizospheric microflora as biological control agents. The biocontrol is a bio-based, eco-friendly approach which offers a realistic and cost-effective alternative to chemical control for the management of plant pathogens [4]. There are some evidences in which antagonistic bacteria and fungi used as biocontrol agents, such as Trichoderma sp. [5,6] Pseudomonas sp. [7,8], and Bacillus sp. [9-11] isolated from rhizosphere niches of different crop and found effective in controlling plant pathogens.
To find the solution to control A. macrospora, a leaf spot pathogen of Bt cotton following objectives was set: i) To screen Bacillus sp. against A. macrospora by dual culture technique and ii) to find the mechanism of biocontrol agent involved in controlling A. macrospora such as production of non-volatile diffusible secondary metabolites, siderophore production, chitinase activity, and evaluation of crude extract by gas chromatography–mass spectrometry (GC–MS) for volatile metabolites.
2. MATERIALS AND METHODS
2.1 Chemicals, Alternaria leaf Spot Pathogen of Bt Cotton, and Bacillus sp.
The chemicals used in this study were procured from M/S HiMedia, Mumbai, and CDH analytical/guaranteed grade chemicals and glass-distilled water were used. A. macrospora, Alternaria leaf spot pathogen of Bt cotton, and Bacillus spp., namely, Bacillus amyloliquefaciens subsp. amyloliquefaciens strain RLS19 (Accession No. MN749553) isolated from infected Bt cotton leaves and rhizospheric soil samples of healthy Bt cotton, respectively, during the previous research work in the Department of Microbiology, Sant Tukaram College of Arts and Science, Parbhani, were used in the present research work.
2.2. Antifungal Action by Dual Culture Technique
B. amyloliquefaciens subsp. amyloliquefaciens strain RLS19 was tested using modified dual culture technique of Skidmore and Dickinson [12] for antifungal activity against A. macrospora. In this modified method, the PDA plate was inoculated with 5 mm fungal disc (5-day-old culture) 10 mm away from the center of the agar plate. Similarly, 24 h old Bacillus amyloliquefaciens subsp. amyloliquefaciens strain RLS19 culture was streaked in opposite direction, 10 mm away from the center of the agar plate to maintain the equidistance of phytopathogen and antagonist from the center of the agar plate. This dual culture experiment was performed in triplicates. A control plate was maintained without streaking bacterial culture. Both the test and control plates were incubated at room temperature for 6 days.
The antifungal activity was calculated by means of measuring the inhibition of radial mycelial growth of fungal pathogen in test as compared to control in terms of percentage inhibition of radial growth (PIRG).
 [Click here to view] |
Where,
R1 – radius of the fungal phytopathogen colony in the control plate
R2 – radius of the fungal phytopathogen colony in the direction of the antagonist colony.
2.3. In Vitro Mechanism of Microbial Control Agent
To search the biocontrol mechanism of microbial control agent, B. amyloliquefaciens subsp. amyloliquefaciens strain RLS19 was tested to produce non-volatile diffusible metabolites, siderophore production, cell wall degrading enzymes, as well as volatile organic bioactive compounds with the help of GC–MS analysis.
2.4. Determination of Antifungal Diffusible Non-volatile Metabolites
The diffusible antifungal non-volatile metabolite was tested by agar well diffusion assay [13]. The King’s B broth inoculated with B. amyloliquefaciens subsp. amyloliquefaciens strain RLS19 and incubated on a rotary shaker at 150 rpm at room temperature for 48 h to get cell-free culture filtrate. On sterile potato dextrose agar plates, a well was punched 1 cm apart from the center on 90 mm diameter Petri plate using sterile cork borer (10 mm). Five millimeters mycelial disc of A. macrospora from leading edge of a 3-day-old culture was punched and kept 1 cm apart from the center and opposite to well in the PDA plate.
Cell-free culture supernatant was prepared from previously inoculated King’s B broth culture by centrifugation at 10,000 rpm using cooling centrifuge at 4°C for 10 min. Cell-free culture filtrate was obtained by filtering cell-free culture supernatant using Millipore Syringe Filter 0.22 m (HiMedia). In aseptic condition, the agar well was loaded with 100 ml cell-free culture filtrate. The control was maintained without loading of cell-free culture filtrate. The inoculated plate was immediately kept in refrigerator to allow diffusion for 2–3 min. Both the plates control as well test were incubated at room temperature for 5–6 days. After the incubation, the plates were observed for the inhibition of radial growth of fungal culture and the % inhibition was calculated [14].
 [Click here to view] |
Where,
R1 is radial growth of the pathogen in control plate (a control value)
R2 is radial growth of the pathogen with antagonist (a test value).
2.5. Siderophore Production
The siderophore production was studied using modified succinate medium [15] consisting (g/l) succinic acid (4), K2HPO4 (6), KH2PO4 (3), (NH4)2 SO4 (1), MgSO4 (0.2), and pH (7.0). 0.1 ml of inoculum of B. amyloliquefaciens subsp. amyloliquefaciens strain RLS19 was inoculated in 250 ml conical flask containing succinate broth and then incubated at room temperature for 72 h on a rotary shaking incubator.
2.5.1. Qualitative and quantitative estimation of siderophore by liquid CAS assay
During incubation, 2 ml of inoculated succinate broth was aseptically removed in 2.5 ml sterile microcentrifuge tube at regular interval of time. The harvested broth samples were centrifuged at 10,000 rpm for 10 min at 4°C to obtain cell-free culture filtrate. The siderophore production was quantitatively determined using Payne [16] method in which 0.5 ml of CAS solution added with 0.5 ml of cell-free culture filtrate. A reference was prepared using the un-inoculated sterile succinate medium. The optical density of both the test and reference was read at 630 nm. The % siderophore units in the culture filtrate were calculated using the following formula.
 [Click here to view] |
Where,
Ar = Absorbance of reference at 630 nm.
As = Absorbance of test sample at 630 nm.
2.6. Detection of Chitinase Enzyme Activity
The chitinase activity of B. amyloliquefaciens subsp. amyloliquefaciens strain RLS19 was tested using colloidal chitin agar [17]. The colloidal chitin agar consists of 6 g Na2HPO4, 3 g KH2PO4, 0.5 g MgSO4, 1 g NH4Cl, 0.5 g NaCl, 0.05 g yeast extract, and 4 g colloidal chitin dissolved in 1000 ml distilled water. The pH of the medium was adjusted to 7.0 and 20 g agar was added as a solidifying agent. The medium was sterilized at 121°C for 20 min and plates were prepared. Chitin agar plate was spot inoculated with bacterial culture and incubated at room temperature for 4 days. The plate was observed for the clear zone of chitin hydrolysis around the spot inoculated culture.
2.7. GC–MS Analysis of Crude Extract
The GC–MS evaluation of cell-free culture filtrate was carried out as per Raut and Hamde [18]. The sterile King’s B broth was inoculated with B. amyloliquefaciens subsp. amyloliquefaciens and incubated on rotary shaking incubator at room temperature for 72 h. After incubation, broth culture was centrifuged at 10,000 rpm at 4°C for 10 min to obtain the crude extract. The GC–MS evaluation of crude extract was performed in IIT Bombay, Powai, Mumbai. The system used with specification GC make version Agilent-7890, with FID detector, Head Space injector, CombiPAL autosampler, and MS make version Jeol AccuTOF-GCV with mass range 10–2000 amu and mass resolution 6000 equipped with VF-5MS (5% phenyl methyl) capillary column of dimensions 30.0 m × 250 mm × 0.25 mm and used helium as carrier gas at 1 ml/min. The column temperature was programmed initially at 60°C followed by an increase of 5 K/min to 270°C and was kept isothermally for 38 min. The constituents were identified using comparison of their mass spectral data with the ones from NIST Library.
3. RESULTS AND DISCUSSION
3.1. Antifungal Action by Dual Culture Technique
B. amyloliquefaciens subsp. amyloliquefaciens strain RLS19 was efficient in inhibiting A. macrospora in dual culture technique whose % inhibition of radial growth was measured and calculated as 98.08 % [Figure 1 and Table 1]. The Chi-square test is applied to data in Table 1. The Chi-square statistic is 27.249, P < 0.00001 and the result is significant at P < 0.05.
| Figure 1: Antifungal action of Bacillus amyloliquefaciens subsp. amyloliquefaciens strain RLS19 against Alternaria macrospora by dual culture technique. [Click here to view] |
Table 1: Antifungal action of rhizospheric isolate Bacillus amyloliquefaciens subsp. amyloliquefaciens strain RLS19 against Alternaria macrospora by dual culture technique.
| S. No. | Rhizospheric isolate | Radial growth of pathogen in control mm (R1) | Radial growth of pathogen in test mm (R2) | % inhibition of radial growth of pathogen |
|---|---|---|---|---|
| 1 | Bacillus amyloliquefaciens subsp. amyloliquefaciens strain RLS19 | 37±0.81 | 0.71±0.008 | 98.08±0.01 |
±Represent standard deviation of tested sample
Earlier researchers had also exploited usefulness of Bacillus subtilis a bioagent was evaluated against A. macrospora of cotton using dual culture technique and substantially inhibited the mycelial growth (73.66%) of the test fungus in vitro [19]. B. subtilis strain 1 was evaluated in vitro against Alternaria leaf spot pathogen of cotton using dual culture technique significantly inhibited the mycelial growth (51.68%) of the test fungus over untreated control [6]. Bioefficacy of three bioagents Trichoderma harzianum, B. subtilis, and Pseudomonas fluorescens tested against A. macrospora by dual culture technique and results revealed that B. subtilis inhibited 71.06% mycelial growth of Alternaria macrospora a phytopathogen of cotton [20]. Similarly, B. subtilis subsp. inaquosorum RLS52 effectively inhibited the radial growth (94.30%) of Alternaria leaf spot pathogen of Bt cotton in dual culture technique [21].
Our rhizobacterial isolate B. amyloliquefaciens subsp. amyloliquefaciens strain RLS19 inhibited A. macrospora in dual culture up to 98.08%, which was far better than the earlier result obtained by Dalpati et al. [19] and Raut et al. [21].
3.2. Determination of Antifungal Diffusible Non-volatile Metabolites
The PDA plates inoculated with 5 mm mycelial disc and agar well inoculated with cell-free culture filtrate of rhizospheric isolate inhibited the mycelial growth of fungal phytopathogen after 6 days of incubation. The results specify that the rhizospheric isolate, B. amyloliquefaciens subsp. amyloliquefaciens strain RLS19 was able to secrete some non-volatile diffusible antifungal secondary metabolites which inhibited the mycelial growth of A. macrospora up to 61.29% Alternaria leaf spot phytopathogen of Bt cotton [Table 2].
Table 2: Detection of antifungal diffusible non-volatile metabolites by rhizospheric isolates against fungal phytopathogen by agar well diffusion method.
| S. No. | Rhizospheric isolate | Radial growth of pathogen in control mm (R1) | Radial growth of pathogen in test mm (R2) | % inhibition of radial growth of pathogen |
|---|---|---|---|---|
| 1 | Bacillus amyloliquefaciens subsp. amyloliquefaciens strain RLS19 | 35±0.81 | 13.55±0.88 | 61.29±3.42 |
±Represent standard deviation of tested sample
The species of Bacillus produces lipopeptides as surfactin, iturin, and fengycin had suppressive mechanisms for the phytopathogens which include parasitism, competition, and antibiosis [22]. Similarly, B. amyloliquefaciens GA1 produced antibiotics and different secondary metabolites including surfactin, fengycin, iturin A, macrolactin, difficidin, bacillaene, and chlorotetaine which contribute in biological management of phytopathogens [23]. Bacillus velezensis exhibits genes for synthesizing secondary metabolites such as cyclic lipopeptides and polyketides to induce systemic resistance in plants [24].
The cell-free extract of B. amyloliquefaciens CNU114001 strain existed antagonism against phytopathogens which include S. sclerotiorum, Colletotrichum orbiculare, Alternaria panax, Pyricularia grisea, Penicillium digitatum, and Botrytis cinerea [25]. Some researchers applied Bacillus sp. to control Alternaria alternata, the causative agent of Alternaria blight of tomato where biocontrol agent releases diffusible non-volatile metabolites [26]. The cultural filtrate of B11-144 (B. amyloliquefaciens) and B11-128 (B. subtilis) possessed the most powerful antifungal activity in opposition to three tested Alternaria sp. [27].
All these reports were indicative that our rhizospheric isolate, B. amyloliquefaciens subsp. amyloliquefaciens strain RLS19 produced diffusible non-volatile secondary metabolites which contributed in inhibition of the mycelial growth of A. macrospora. These diffusible non-volatile secondary metabolites needed to be further identified.
3.3. Qualitative and Quantitative Estimation of Siderophore by Liquid CAS Assay
The fermented succinate broth samples harvested after the specified interval of time (24, 36, 48, 60, and 72 h) and centrifuged at 10,000 rpm in a cooling centrifuge for 10 min to get cell free culture filtrate. In qualitative estimation of siderophore, 0.5 ml cell-free culture filtrate mixed with 0.5 ml of CAS reagent showed the change in color from blue to orange indicates siderophore production [Figure 2].
 | Figure 2: Qualitative estimation of siderophore production by Bacillus amyloliquefaciens subsp. amyloliquefaciens strain RLS19 by liquid CAS assay. [Click here to view] |
Similarly for quantitative estimation, the optical density of the test and reference was read at 630 nm using UV spectrophotometer and recorded. The % siderophore unit produced [Table 3] by rhizospheric bacterial isolate in the cell-free culture filtrate was calculated [16]. B. amyloliquefaciens subsp. amyloliquefaciens RLS19 produced highest siderophore units (93.20%) after 60 h. The subsequent incubation after 60 h there was a slight decrease in % siderophore units and it was due to degradation of produced siderophore.
Table 3: Quantitative estimation of siderophore produced by rhizospheric isolate using liquid CAS assay.
| S. No. | Rhizospheric isolate | Siderophore units (%) | ||||
|---|---|---|---|---|---|---|
| 24 h | 36 h | 48 h | 60 h | 72 h | ||
| 1 | Bacillus amyloliquefaciens subsp. amyloliquefaciens strain RLS19 | 24.34 | 76.28 | 88.14 | 93.20 | 87.93 |
Some fungi and bacteria are able to produce low-molecular-weight ferric ion chelating compound called siderophore. Members of genus Bacillus can secrete a catechol-based siderophore called bacillibactin. The biocontrol agent B. amyloliquefaciens GA1 having a gene shown to direct the synthesis the iron siderophore bacillibactin [23]. The genomic analysis of B. amyloliquefaciens SQR9 strain identified dhbE-A gene which is responsible for the synthesis of bacillibactin and suppresses the different soil-borne fungal phytopathogens [28].
The plant growth-promoting rhizobacterial isolate B. amyloliquefaciens strain sks_bnj 1 produced 82.35% siderophore units [29]. Furthermore, the siderophore production of B. subtilis CTS-G24 in different media such as succinate broth and nutrient broth was studied it was reveals that strain was able to produce 64% and 59% siderophore, respectively, and participates in inhibiting the fungal plant pathogens of chickpea [30]. Similarly, the bioagents and PGP strains of B. subtilis-1 and Bacillus megaterium-1 evaluated for siderophore production quantitatively, both the strains produced (65.00%) and (50.27%) siderophore units, respectively [31]. B. subtilis subsp. inaquosorum RLS52 produced 85.04% siderophore unit while the time of harvesting of highest siderophore from fermentation broth was 72 h and with subsequent incubation, there was a decrease in % siderophore units [21].
In the present study, B. amyloliquefaciens subsp. amyloliquefaciens strain RLS19 produced 93.20% siderophore units after 60 h, it was found better than the previous researchers Sharma et al. [29] and Raut et al. [21] in terms of siderophore production units. Siderophore production ability of isolate also contributed in mycelial growth inhibition of Alternaria leaf spot phytopathogen of Bt cotton.
3.4. Detection of Chitinase Enzyme Activity
The chitinase production ability of rhizobacterial isolates B. amyloliquefaciens subsp. amyloliquefaciens strain RLS19 tested by chitin agar plate assay which shown the zone of chitin hydrolysis surrounding the colony [Figure 3]. The zone of chitin hydrolysis surrounding the colony indicates the presence potent chitin-hydrolyzing enzyme. The chitinase activity was measured and recorded in mm [Table 4].
 | Figure 3: Detection of chitinase enzyme activity of Bacillus amyloliquefaciens subsp. amyloliquefaciens strain RLS19 by colloidal chitin agar plate assay. [Click here to view] |
Table 4: Detection of chitinase enzyme activity of rhizospheric isolates by colloidal chitin agar plate assay.
| S. No. | Rhizospheric isolates | Total zone of hydrolysis including colony (mm) | Diameter of colony (mm) | Diameter zone of chitin hydrolysis (mm) |
| 1 | Bacillus amyloliquefaciens subsp. amyloliquefaciens strain RLS19 | 18 | 9 | 9 |
An insoluble structural polysaccharide, that is, chitin found within the cell walls of insects and fungi. Chitinases are hydrolytic enzymes which will convert polysaccharide into low molecular mass, soluble, and insoluble oligosaccharides [32]. In general, enzyme chitinase found in organisms useful to reshape their own chitin or degrade and digest the chitin of fungi by breaking the glycosidic bonds in chitin. Chitinolytic enzymes are important due to their biocontrol applications, especially the Chitinases useful in agriculture to manage fungal phytopathogens. The chitinase production ability of B. amyloliquefaciens 1st time recorded by researcher Sabry [33].
Some researchers reported that B. amyloliquefaciens V656 strain grown in a medium amended with marine waste crab and shrimp shell powder produces the extracellular antifungal enzymes [34]. B. subtilis isolated from soil sample having antifungal activity against plant pathogen was evaluated for chitinase activity and showed 0.6 mm zone of clearance surrounding the colony on colloidal chitin agar plate [35]. Bacillus licheniformis and B. subtilis produced prominent and maximum clear zone of chitin hydrolysis as 14 mm and 11 mm, respectively, on colloidal chitin agar medium [36]. Furthermore, the rhizospheric isolate B. subtilis subsp. inaquosorum RLS52 having antifungal activity against A. macrospora, a leaf spot phytopathogen of Bt cotton produced 7.3 mm clear hallo around the colony [21].
In the present research, B. amyloliquefaciens subsp. amyloliquefaciens strain RLS19 produced the 9 mm clear zone of chitin hydrolysis which was better than the results obtained by Raut et al. [21] and Karunya [35] but less chitinase enzyme activity than Abirami et al. [36]. These results indicate that the chitinase enzyme produced by our rhizospheric isolate confirmed the important role in controlling Alternaria leaf spot phytopathogen of Bt cotton.
3.5. GC–MS Analysis of Crude Extract
The crude extract of B. amyloliquefaciens subsp. amyloliquefaciens strain RLS19 was evaluated to detect the biologically active novel volatile compounds having accountability to suppress the fungal phytopathogens using GC–MS analysis. The novel volatile compounds were identified based on a comparison of the peaks of chromatogram with mass spectral data from NIST (2007) library.
B. amyloliquefaciens subsp. amyloliquefaciens strain RLS19 showed six peaks in the GC–MS chromatogram. Based on peak abundance, three peaks of chromatogram compared to mass spectral data from NIST (2007) Library. The GC–MS spectral results compared with library search successfully identified three compounds. The biologically active compounds with their retention time, molecular weight, molecular formula, structure, and percentage of similarity, and biological activity recorded in Table 5. The GC–MS evaluation of cell-free culture filtrate rhizospheric isolate B. amyloliquefaciens subsp. amyloliquefaciens strain RLS19 detected three compounds, namely, 2,5-Piperazinedione, 3,6-bis(2-methylpropyl)-; acetamide, N-methyl-N-[4-(3-hydroxypyrrolidinyl)-2-butynyl]-, and pyrrolo[1,2-a]pyrazine-1,4-dione, hexahydro-. Some researchers reported the antifungal activity of 2,5-piperazinedione 3,6-bis(2-methylpropyl)- produced by Lactobacillus plantarum AF1 against Aspergillus flavus ATCC 22546 [37]. The crude extract of Streptomyces indiaensis after GC–MS analysis revealed major constituents as 3-Pyrrolidin-2-yl-propionic acid; pyrrolo{1,2-a}pyrazine-1,4-dioe,hexahydro-; benzamide, N-propyl pyrrolo{1,2-a}pyrazine-1,4-dione,hexahydro-3-(2-methylpropyl)-; Tetradecane,2,6,10-trimethyl; 5,10-Diethoxy-2,3,7,8-tetrahydro-1H,6H-dipyrrolo{1,2-a;1,2-d}pyrazine; and chloroxylenol which showed antifungal activity against F. oxysporum [38]. To discover the volatile metabolite and mechanism of antifungal potential, the crude extract of endophytic B. amyloliquefaciens BmB 1 having antagonistic activity against Rhizoctonia sp. and Pythium sp. [39] was analyzed to detect the volatile compounds by GC–MS analysis and confirmed the presence of benzene acetic acid; diisooctyl phthalate; octadecanoic acid; pyrrolo[1,2-a]pyrazine-1,4-dione hexahydro-; 2,5-Piperazinedione,3-benzyl-6-isopropropyl; pyrrolo[1,2-a]pyrazine-1,4-dione hexahydro-3-(phenylmethyl); and pyrrolo[1,2-a]pyrazine-1,4-dione hexahydro-3-(2-methylpropyl).
Table 5: Biochemical compounds identified in crude extract of Bacillus amyloliquefaciens subsp. amyloliquefaciens strain RLS19 by GC-MS.
| Retention time | Name of the compound | Formula | Structure | Mol. Wt. g/mol | Similarity (%) | Biological activity |
|---|---|---|---|---|---|---|
| 16.73 | Pyrrolo[1,2-a]pyrazine-1,4-dione, hexahydro- | C7H10N2O2 |  | 154 | 76.3 | Antimicrobial Algicidal |
| 25.07 | 2,5-Piperazinedione,3,6-bis(2-methylpropyl)- | C12H22N2O2 |  | 226 | 62.3 | Antifungal |
| 25.42 | Acetamide, N-methyl-N-[4-(3-hydroxypyrrolidinyl)-2-butynyl]- | C11H18N2O2 |  | 210 | 23.4 | Antimicrobial |
Similarly, GC–MS analysis of crude extract of Bacillus sp. WG4 reveals the presence of pyrrolo[1,2-a] pyrazine-1,4-dione, hexahydro derivative such as pyrrolo[1,2-a] pyrazine-1,4-dione, hexahydro-3-(phenylmethyl) as basis of antifungal activity against Pythium myriotylum [40]. Two Bacillus strains isolated from Krubera-Voronja Cave, the strain 1410WF1-TSA30-2 is 1,2-benzenedicarboxylic acid, bis(2-methylpropyl) ester and the strain 1350R2-TSA30-6 shown to produce volatile chemical compounds such as pyrrolo[1,2-a]pyrazine-1,4-dione, hexahydro-3-(phenylmethyl)-, and pyrrolo[1,2-a]pyrazine-1,4-dione, hexahydro- 3-(2-methylpropyl)-with antibacterial activity [41]. Furthermore, the characterization of the crude extract of Bacillus pumilus MMM by GC–MS and confirms the availability of biologically active compounds pyrrolo[1,2-a]pyrazine-1,4-dione derivatives having inhibitory effect against Vibrio parahaemolyticus, Pseudomonas aeruginosa, and Staphylococcus aureus [42]. Crude extract of sponge endosymbiotic Bacillus sp. analyzed by GC–MS and reveals the presence of pyrrolo[1,2-a]pyrazine-1,4-dione, hexahydro-, having antibacterial activity [43].
All these reports indicate that B. amyloliquefaciens subsp. amyloliquefaciens strain RLS19 produced volatile compounds 2,5-Piperazinedione, 3,6-bis(2-methylpropyl)-; Acetamide, N-methyl-N-[4-(3-hydroxypyrrolidinyl)-2-butynyl]-, and pyrrolo[1,2-a] pyrazine-1,4-dione, hexahydro- and the inhibitory activity against A. macrospora, an Alternaria leaf spot phytopathogen of Bt cotton.
4. CONCLUSION
Overall results suggest that B. amyloliquefaciens subsp. amyloliquefaciens strain RLS19 inhibited the mycelial growth of A. macrospora, Alternaria leaf spot phytopathogen of Bt cotton. All though searching biocontrol mechanism, the strain was able to produce non-volatile secondary metabolites, siderophore, chitinase enzyme, and volatile organic bioactive compounds which includes pyrrolo[1,2-a]pyrazine-1,4-dione, hexahydro-; 2,5-Piperazinedione, 3,6-bis(2-methylpropyl)-, and acetamide, N-methyl-N-[4-(3-hydroxypyrrolidinyl)-2-butynyl]- which contributed in inhibition of mycelial growth of fungal phytopathogen. Due to the presence of multiple potentialities, B. amyloliquefaciens subsp. amyloliquefaciens strain RLS19 can serve as an excellent biocontrol candidate for the management of Alternaria leaf spot pathogen of Bt cotton and alternative to agrochemicals. Furthermore, this strain needs to test for inhibitory activity in opposition to various phytopathogens of different crops.
5. CONFLICTS OF INTEREST
Authors declared that they do not have any conflicts of interest.
6. AUTHOR CONTRIBUTIONS
All authors made substantial contributions to conception and design, acquisition of data, or analysis and interpretation of data; took part in drafting the article or revising it critically for important intellectual content; agreed to submit to the current journal; gave final approval of the version to be published; and agree to be accountable for all aspects of the work.
7. FUNDING
There is no funding to report.
8. ETHICAL APPROVALS
This study does not involve the use of animals or human subjects.
REFERENCES
1. Hillocks RJ.
2. Bashan Y, Levanony H, Or R. Association between
3. Hosagoudar GN, Chattannavar SN, Benagi VI, Adiver SS, Patil SB, Ashtaputre AS,
4. Mark GL, Morrissey JP, Higgins P, O'Gara F. Molecular-based strategies to exploit
5. Meena M, Swapnil P, Zehra A, Dubey MK, Upadhyay RS. Antagonistic assessment of
6. Prasad BM, Bhattiprolu SL, Kumari PV, Kumar PA.
7. Duke KA, Becker MG, Girard IJ, Millar JL, Fernando WD, Belmonte MF,
8. Zain M, Yasmin S, Hafeez FY. Isolation and characterization of plant growth promoting antagonistic bacteria from cotton and sugarcane plants for suppression of phytopathogenic
9. Khiyami MA, Omar MR, Abd-Elsalam KA, Aly AA.
10. Ramzan M, Tabassum B, Nasir IA, Khan A, Tariq M, Awan MF,
11. Xiang N, Lawrence KS, Donald PA. Biological control potential of plant growth-promoting rhizobacteria suppression of
12. Skidmore AM, Dickinson CH. Colony interactions and hyphal interference between
13. Schlumbaum A, Mauch F, Vögeli U, Boller T. Plant chitinases are potent inhibitors of fungal growth. Nature 1986;324:365-7. [CrossRef]
14. Whipps JM. Effect of media on growth and interactions between a range of soil-borne glasshouse pathogens and antagonistic fungi. New Phytol 1987;107:127-42. [CrossRef]
15. Meyer JA, Abdallah MA. The fluorescent pigment of
16. Payne SM. Detection, isolation, and characterization of siderophores. Methods Enzymol 1994;235:329-44. [CrossRef]
17. Hsu SC, Lockwood JL. Powdered chitin agar as a selective medium for enumeration of actinomycetes in water and soil. Appl Microbiol 1975;29:422-6. [CrossRef]
18. Raut LS, Hamde VS.
19. Dalpati NN, Parate RL, Ingle ST. Efficacy of some bio-agents and botanicals against
20. Bodhke VS, Patil CU, Zade, SB. Evaluation of fungicides and bio-agents against
21. Raut LS, Rakh RR, Hamde VS.
22. Bonmatin JM, Laprévote O, Peypoux F. Diversity among microbial cyclic lipopeptides:Iturins and surfactins. Activity-structure relationships to design new bioactive agents. Comb Chem High Throughput Screen2003;6:541-56. [CrossRef]
23. Arguelles-Arias A, Ongena M, Halimi B, Lara Y, Brans A, Joris B,
24. Rabbee MF, Ali M, Choi J, Hwang BS, Jeong SC, Baek KH.
25. Ji SH, Paul NC, Deng JX, Kim YS, Yun BS, Yu SH. Biocontrol activity of
26. Pane C, Zaccardelli M. Evaluation of
27. Ali GS, El-Sayed AS, Patel JS, Green KB, Ali M, Brennan M,
28. Li B, Li Q, Xu Z, Zhang N, Shen Q, Zhang R. Responses of beneficial
29. Sharma SK, Ramesh A, Johri BN. Isolation and characterization of plant growth-promoting
30. Patil S, Bheemaraddi MC, Shivannavar CT, Gaddad MS. Biocontrol activity of siderophore producing
31. Ghosh SK, Pal SU, Chakraborty NI. The qualitative and quantitative assay of siderophore production by some microorganisms and effect of different media on its production. Int J Chem Sci 2015;13:1621-9.
32. Kramer KJ, Muthukrishnan S. Insect chitinases:Molecular biology and potential use as biopesticides. Insect Biochem Mol Biol 1997;27:887-900. [CrossRef]
33. Sabry SA. Microbial degradation of shrimp-shell waste. J Basic Microbiol 1992;32:107-11. [CrossRef]
34. Wang SL, Shih IL, Liang TW, Wang CH. Purification and characterization of two antifungal chitinases extracellularly produced by
35. Karunya SK. Optimization and purification of chitinase produced by
36. Abirami S, Yogalsakshmi K, Pushpa AS, Kananan M. Screening and identification of chitin degrading bacteria from shrimp shell waste dumping soil environment and its media optimization for chitinase enzyme production. World J Pharm Pharm Sci 2016;5:743-57.
37. Yang EJ, Chang HC. Purification of a new antifungal compound produced by
38. Jalaluldeen AM, Sijam K, Othman R, Ahmad ZA. Growth characteristics and production of secondary metabolites from selected
39. Jasim B, Benny R, Sabu R, Mathew J, Radhakrishnan EK. Metabolite and mechanistic basis of antifungal property exhibited by endophytic
40. Jimtha JC, Jishma P, Arathy GB, Anisha C, Radhakrishnan EK. Identification of plant growth promoting rhizosphere
41. Klusaite A, Vickackaite V, Vaitkeviciene B, Karnickaite R, Bukelskis D, Kieraite-Aleksandrova I,
42. Malash MA, El-Naggar MM, Abou HE, Hassayeb El, Ibrahim MS. Production of antimicrobial pyrrol-derevatives acting against some fish pathogens from marine
43. Mohan G, Thangappanpillai A, Ramasamy B. Antimicrobial activities of secondary metabolites and phylogenetic study of sponge endosymbiotic bacteria,